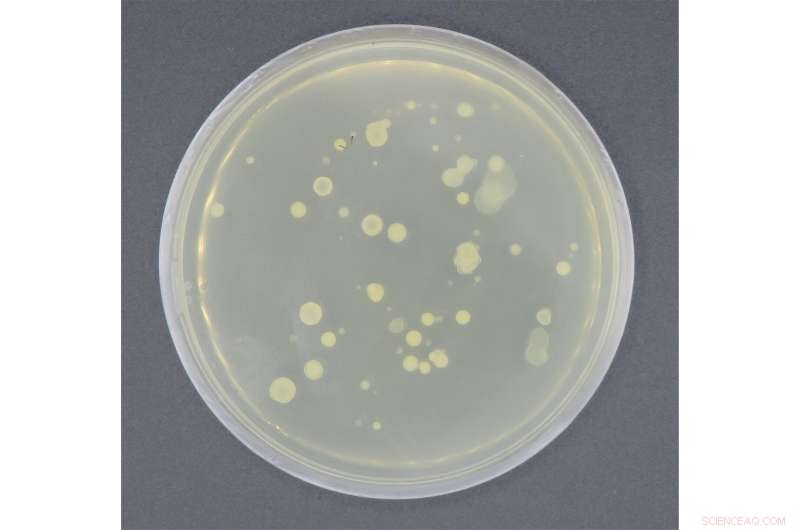
Decontaminating Almonds & Nuts with Compressed CO₂: A Safer Food Technology

The bacterial culture is plated out in a nutrient medium. Credit: Karen Fuchs/Fraunhofer UMSICHT
Hardly a day goes by without manufacturers recalling food tainted by impurities. Even dry foods, generally thought to be safe because they lack the water pathogens needed to thrive, are often pulled from store shelves. Harmful microorganisms, such as salmonella, can colonize these foods during processing. Almonds, a popular treat around Christmastime, are one of the mo-re susceptible foods. Now researchers at the Fraunhofer Institute for Environment, Safety, and Energy Technology UMSICHT have developed a new process to kill off germs that befall almonds and nuts: using compressed carbon dioxide to decontaminate food.
According to the German consumer protection agency, the number of food recalls rose rapidly between 2015 and 2019. If a product poses a health risk, the manufacturer has to take it off the market and notify consumers. Processing can affect the quality of food, particularly that of plant-based products that are consumed raw. They may be contaminated with salmonella that cause food poisoning. These bacteria can even spread to dry foods, which experts call products with low water activity. This group of low-moisture foods includes almonds, nuts, dried fruits, spices, milk powder and even tea.
"Salmonella can go dormant to survive on almonds. In the process, they produce additional biomass that protects them from desiccation. If water enters the picture, salmonella then proliferate explosively. But it takes just ten to one hundred of these bacteria to cause food poisoning. Contaminated almonds that make their way into production facilities after harvesting can also contaminate other batches," says Karen Fuchs, a researcher at Fraunhofer UMSICHT in Oberhausen. In a joint project with the University of Alberta in Canada, she and her team investigated technologies that could serve to decontaminate almonds. The German Federal Ministry of Education and Research (BMBF) funded this research venture called MiDeCO2.
"It is common knowledge that pressurized carbon dioxide can kill pathogenic bacteria in liquids such as orange juice. Our research has shown that under certain conditions this also works with dry food," says Fuchs. Carbon dioxide is not harmful to the environment or health and can be separated from almonds without a trace of residuals. This does not involve any energy-intensive steps for purification.

These almonds have been treated in a high-pressure autoclave. Pressure build-up and pressure reduction speed is a decisive factor in maintaining the quality. Credit: Karen Fuchs/Fraunhofer UMSICHT
Retaining the flavor of almonds
In one process step almonds are decontaminated and impregnated with antimicrobial oils using compressed carbon dioxide in a high-pressure autoclave. The oil extract coats the almond, making it difficult for germs to recontaminate the fruit. The advantage of this process is that almonds retain their characteristic flavor and quality. Fuchs and her team carried out tests with Staphylococcus carnosus, a surrogate organism known for an even more resistant reaction than salmonella, proving that the process in the autoclave does not adversely affect the shelf life, rancidity or lipid composition of almonds. "The oils are not just antibacterial; they also have antioxidant properties. They increase the oxidation potential and extend the shelf life of fats, meaning that almonds are not as quick to go rancid," says the researcher. She goes on to say that the antibacterial and anti-oxidative properties are not the only potential benefit. Increasing the amount of oils that harmonize well with almonds' flavor could also add a tasty touch of seasoning. This process also lends itself to other foods. The increased lipid oxidation potential could benefit any food that is prone to oxidation.